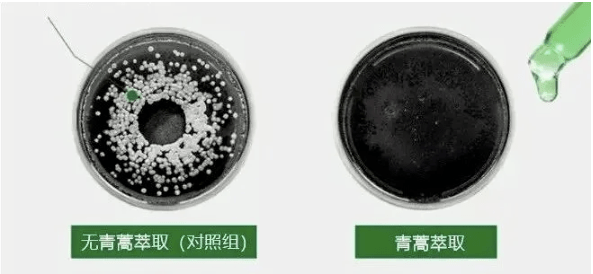
尸体头上抠下来的白泥竟是螨虫尸体!头痒头屑出油多,用它就对了

文章图片
 头皮环境绿色健康 , 脱发问题也改善了 。 
 
文章图片
 (使用效果因人而异)
 还添加黄花蒿、马齿苋天然植萃+10种氨基酸成分 , 养发护发 , 让每一根发丝都吸饱营养 , 精致到发梢~
 有了它 , 你也能拥有女明星同款 海藻般的秀发!
 
文章图片
 强烈推荐理由
 1、诺贝尔青蒿成分 , 除螨去屑有保障;
 2、多种植萃提取物 , 深层修复滋养;
 3、氨基酸洗发水 , 温和不刺激;
 4、蓝风铃调香 , 洗出香软蓬松发质
 01
 mvo专业药妆品牌
 青蒿素去屑除螨 , 拯救头皮
 这款青蒿植萃洗发水由 英国药妆制药品牌——mvo开发, 药学博士CEUO带领50余名教授和皮肤科医生历经4年研发而成 。
 
文章图片
 2015年 , 屠呦呦女士发现了青蒿素获得诺贝尔奖 , 是全中国的骄傲 。 
 
文章图片
 科学家们经过深入研究和实验 , 发现青蒿素在 抑制头皮螨虫 , 缓解头痒、头屑、出油方面也有优异的表现 。
文章图片
 mvo研发团队将这一研究成果应用到洗发水中 , 采用 植物配方 , 温和清洁养发 。
 
文章图片
 添加狭叶青蒿中提取的青蒿精华 , 它能 穿透螨虫薄膜皮 , 让螨虫虚弱、脱水而死 。
 
文章图片
 CEUO博士做了实验 , 把螨虫放在切片上 , 显微镜观察下螨虫鲜活有力 ,看来没少糟蹋你的头皮 。 
 
文章图片
 ?蠕形螨在蠕动?
 滴入高浓度青蒿成分 , 没过5分钟 , 螨虫就一动不动 , 僵死了过去 。 
 
文章图片
 ?蠕形螨被杀死了?
 相比传统的硫酸、海盐成分 , 青蒿除螨更加温和有效 , 而且能调理皮脂分泌 , 让重度出油的头皮恢复清爽 , 堵塞毛囊根部的油脂颗粒都“一扫而光” 。 
 
文章图片
 还添加黄花蒿、马齿苋提取物 , 两者都是 天然消炎止痒的植物 , 能够有效避免抓挠产生头屑 。
 
文章图片
 实验室做过数千次的真人实验 , 将富含多种植物精粹的洗发水涂在头皮上 , 伤痕累累的毛囊很快被修复 , 头皮重新恢复成一片“沃土” 。 
 
文章图片
 
文章图片
 送去第三方微生物分析中心严格检测 , 除螨率高达99.9%!这可是实打实的数据 , 不是市面上普通除螨洗发水能比拟的 。 
 
经验总结扩展阅读
- 卷发绝美新年公主编发,我想焊死在头上!
- 奚梦瑶 奚梦瑶产后晒减肥健身照!额头上挂满汗珠,穿紧身裤一双细腿抢眼
- 贺峻霖 贺峻霖第二波“大动作”来了!粉丝:把露额头发型焊在头上
- 偏方迷惑丨为什么额头上的闭口总是反反复复的?
- georgy kot 外国发型师打造奇葩礼帽发型,这个顶在头上真的不重吗
- 人脸明星光环下的TST受害者:有人脸脱皮六次,有人纱布捆手防抠脸
- 发型 头上能干这么多事!女明星奇葩发型数不完,丑拒,但笑得捂不住嘴
- 发型头上能干这么多事!女明星奇葩发型数不完,丑拒,但笑得捂不住嘴
- 护肤 女明星馨子自曝为减肥催吐!吃完就去厕所抠嘴,每天只吃一个苹果
- 脏辫 直男最“反感”女生这4种发型:哪吒头上榜,第4个似“老婆婆”

 
   
   
   
   
   
   
   
   
   
   
   
  